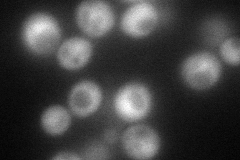
YNR012W
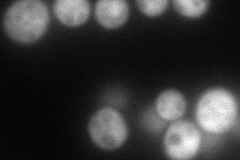
YNR012W
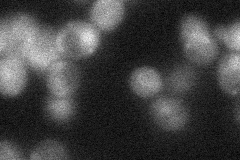
YNR012W
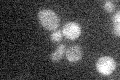
YNR012W

View description
Uridine/cytidine kinase, component of the pyrimidine ribonucleotide salvage pathway that converts uridine into UMP and cytidine into CMP; involved in the pyrimidine deoxyribonucleotide salvage pathway, converting deoxycytidine into dCMP
Localization:
Intensity:
Fold change:
Significance:
-
C’ GFP library in SD

nucleus25.93 -
N' NOP1pr-GFP in SD
cytosol109.454 -
N' TEF2pr-mCherry in SD
punctate123.484 -
N' NATIVEpr-GFP in SD
below threshold25.6799 -
N' TEF2pr-VC and Cyto-VN in SD

#N/A0 -
C’ GFP library in SD+DTT

nucleus20.50.79No -
C’ GFP library in SD+H2O2

nucleus22.260.85No -
C’ GFP library in Starvation Media
nucleus16.720.64Yes -
C’ GFP library on the background of Pup2-DaMP

nucleus -
C’ GFP library on the background of CCT mutant

nucleus31.61441.21883No
